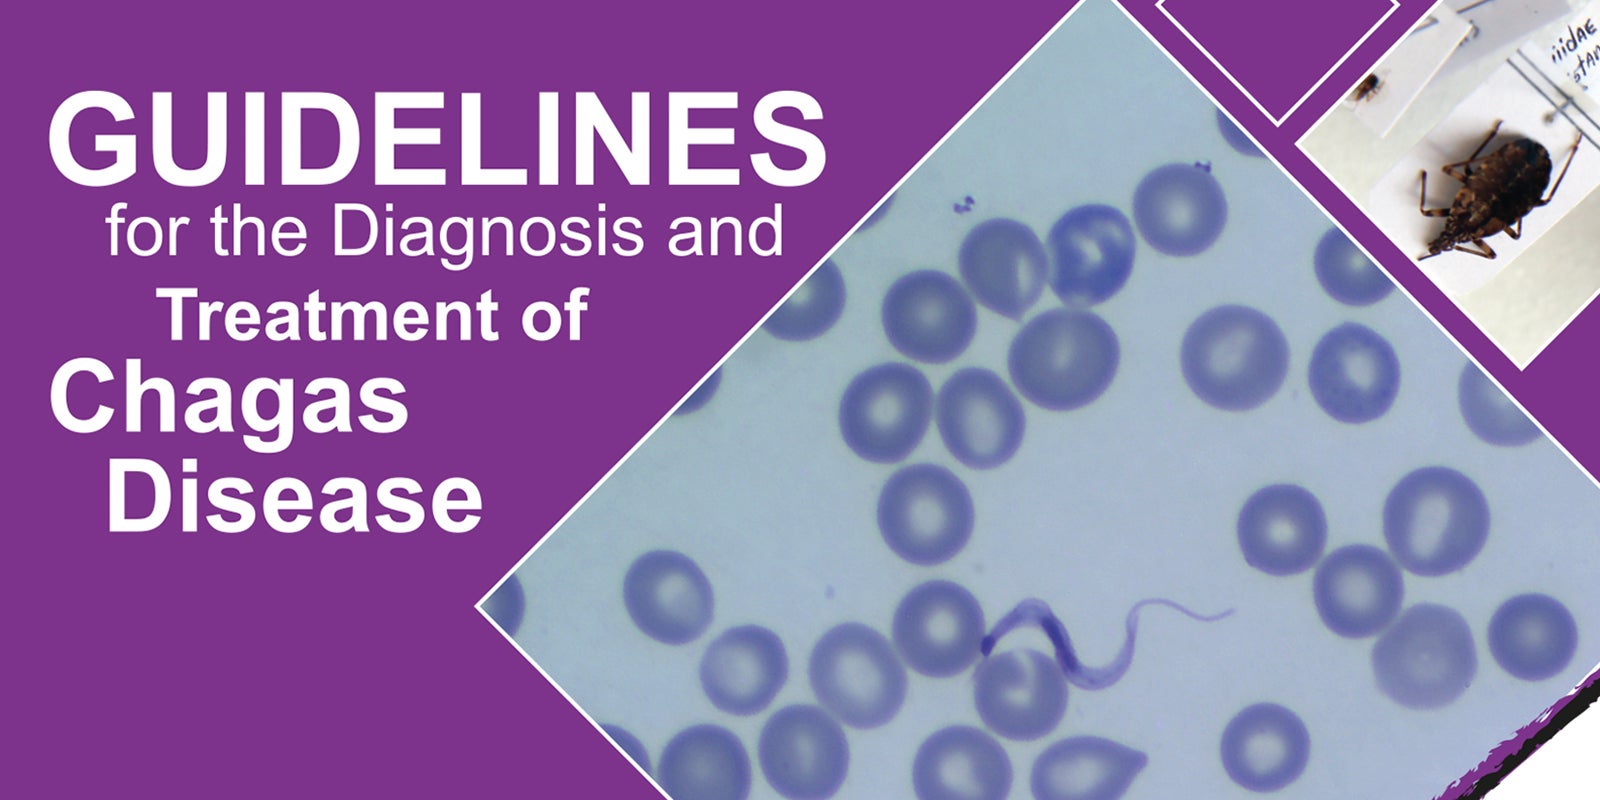
Chagas guidelines

7 de janeiro de 2019 – Cerca de 65 milhões de pessoas que vivem em 21 países endêmicos das Américas correm o risco de contrair a doença de Chagas, uma infecção parasitária que atinge cerca de 12 mil vidas na região a cada ano. Para melhorar a detecção e o manejo clínico da doença, a Organização Pan-Americana da Saúde (OPAS) publicou um novo guia para o diagnóstico e o tratamento da doença de Chagas, por enquanto disponível apenas em espanhol.
A doença de Chagas, ou tripanossomíase americana, é causada pelo parasito Trypanosoma cruzi e pode ser transmitida por meio de insetos, transfusões de sangue, de mãe para filho durante a gestação ou parto e por alimentos. Mais de 6 milhões de pessoas nas Américas vivem com Chagas; a maioria delas não sabe que está infectada. Estima-se que 28 mil novos casos ocorrem por transmissão vetorial e outros 8 mil novos casos por transmissão congênita.
Todas essas características fazem da doença de Chagas uma patologia regional com impacto negativo em saúde pública e com potencial de dispersão para outros continentes por transmissão congênita e sanguínea. No entanto, os profissionais de saúde da região se mantêm e trabalham com poucas informações, bem como com capacitação mínima. Por isso, o guia se propõe a fortalecer as capacidades desses profissionais para diagnosticar e tratar a doença de forma oportuna e adequada, incluindo o manejo clínico integral.
O novo guia procura preencher estas lacunas, fornecendo procedimentos mais claros e padronizados para melhorar o atendimento e o tratamento para cada pessoa infectada, com o objetivo de contribuir para uma melhor saúde entre pacientes, suas famílias e comunidades.
O documento foi desenvolvido por especialistas renomados e é baseado em evidências avaliadas com a metodologia GRADE (Grading of Recommendations Assessment, Development and Evaluation), fornecendo uma síntese de evidências atualmente conhecidas e publicadas sobre o assunto.
Clique na imagem abaixo para acessar o guia